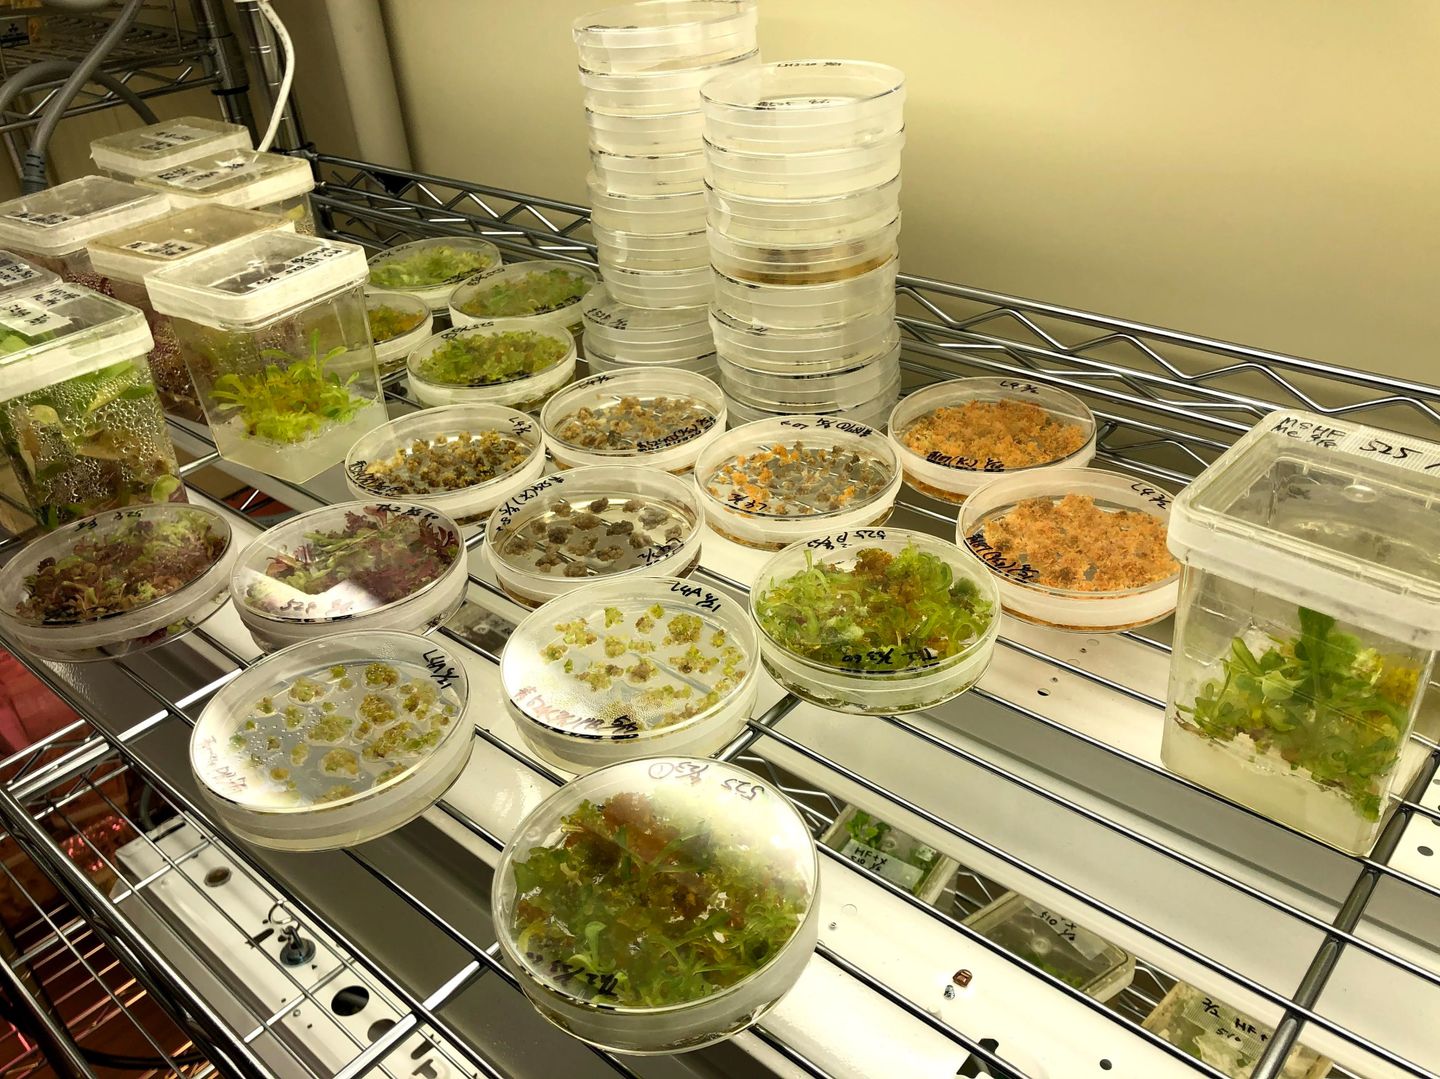

植物組織培養や遺伝子組換え技術を用いた花色や葉色の改変
まだ、この世界にない色で、植物の観賞価値を高める
植物組織培養・遺伝子組換え技術を用いた観賞価値の高い植物の育成を行っています。組織培養技術とは、植物の細胞や組織から植物体を再生させる技術のことで、培養技術の確立と大量増殖を目指します。また、遺伝子組換え技術では、植物に特定遺伝子を導入することで、交配育種だけでは作出困難な作物をつくることができます。これらを組み合わせることによって、園芸作物の効率的な繁殖と新品種の育成を目的として研究を行っています。